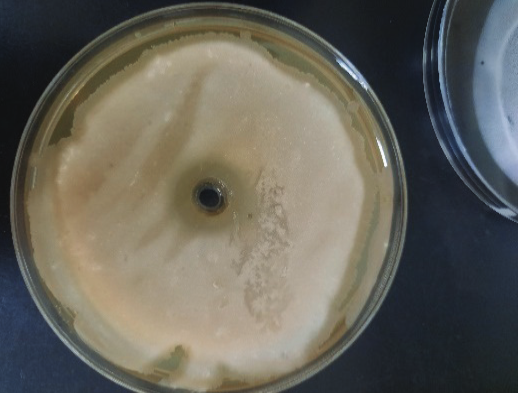
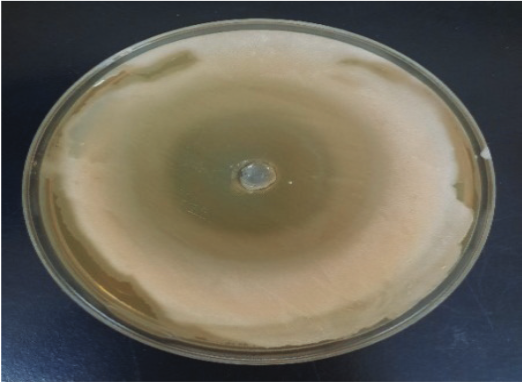

Từ lâu, sả đã được sử dụng nhiều để trị các bệnh cảm cúm, cảm lạnh thông thường. Đã có một số nghiên cứu trong và ngoài nước về thành phần hóa học và hoạt tính sinh học của loài này. Tuy nhiên, vẫn chưa có báo cáo về thành phần hóa học và hoạt tính kháng khuẩn của cây sả trồng tại huyện Tây Giang, tỉnh Quảng Nam, Việt Nam. Mục tiêu của nghiên cứu này hướng tới xác định thành phần hóa học của tinh dầu sả hương Tây Giang bằng sắc ký khí kết hợp với khối phổ (GC-MS) và bước đầu đánh giá khả năng kháng khuẩn đối với ba chủng vi khuẩn: B. subtilis, Salmonella và E. coli bằng phương pháp khuếch tán đĩa thạch của tinh dầu sả hương Tây Giang (Cymbopogon winterianus Jowitt.). Kết quả phân tích đã xác định được 26 cấu tử có trong thành phần của tinh dầu sả hương Tây Giang, trong đó ba thành phần chính là citronellal (48,84%), citronellol (9,73%) và geraniol (19,75%). Hơn nữa, nghiên cứu cho thấy tinh dầu sả hương Tây Giang biểu hiện hoạt tính kháng khuẩn trên 2 chủng là B. subtilis và E. coli với giá trị MIC là 48,15 mg/ml, trong đó hoạt tính kháng khuẩn biểu hiện mạnh hơn trên chủng E.coli và không biểu hiện kháng khuẩn đối với chủng Salmonella. Những kết quả này góp phần tạo thêm ứng dụng cho tinh dầu sả hương Tây Giang, khai thác tiềm năng và nâng cao giá trị của loại cây này.
Đặt vấn đề
Chi Sả ở nước ta có khoảng 15 loài trong đó 2 loại sả được trồng phổ biến nhất là sả chanh – Lemongrass (Cymbopogon citratus Stapf) và sả Java – Citronella (Cymbopogon winterianus Jowitt). Cây sả hương Tây Giang là tên gọi địa phương tại huyện Tây Giang, tỉnh Quảng Nam, thuộc loài Cymbopogon winterianus Jowitt. Tinh dầu sả hương Tây Giang chứa nhiều cấu tử khác với sả Java được trồng ởnơi khác. Tuy nhiên, sả hương Tây Giang chưa được nghiên cứu sâu để tăng khả năng ứng dụng trong chăm sóc sức khỏe cộng đồng.Cây sả ở huyện Tây Giang phát triển tốt ở độ cao trên 600 m, càng cao lượng tinh dầu tích tụ trong lá càng lớn. Cây sả rất phù hợp với 10 xã ở huyện Tây Giang, tổng diện tích trồng sả hiện tại là 110 ha với 195 hộ dân, dự kiến sẽ phát triển trên toàn huyện với tổng diện tích 550 ha, nâng số hộ dân tham gia lên 650 hộ, đạt khoảng 16.650 tấn lá sả/ha/năm. Hàm lượng tinh dầu trong lá sả hương Tây Giang cao gấp 4 lần so với cây sả khác. Đây là giống sả có hàm lượng tinh dầu cao, chất lượng tinh dầu tốtnên rất cần nghiên cứu để ứng dụng cho việc chăm sóc sức khỏe cộng đồng.
Nhiều nghiên cứu về tinh dầu sả đã chỉ ra rằng, tinh dầu sả có khả năng kháng lại một số vi sinh vật, đặc biệt là vi khuẩn gây bệnh. Việc sử dụng kết hợp các loại tinh dầu với các hợp chất chiết từ thực vật trong các sản phẩm là một xu hướng phát triển trong công nghiệp dược hiện đại. Các nghiên cứu trong và ngoài nước cho thấy khả năng kháng được vi khuẩn gram âm, vi khuẩn gram dương, nấm men, nấm mốc của nhiều loại tinh dầu sả khác nhau. Tính kháng khuẩn của tinh dầu được chứng minh là do sự hiện diện của một số hoạt chất như citral, geraniol, phenol, terpen và aldoketone. Nhiều công bố đã cho thấy, các loại tinh dầu sả có khả năng ức chế một số loại vi khuẩn, chống oxy hóa, chống viêm, giải cảm, ngăn cản phát triển của côn trùng… Do vậy, tinh dầu sả đã được ứng dụng trong một số sản phẩm như: nước rửa tay, nước xịt côn trùng, tinh dầu massage, nước xịt khử mùi…
Xu hướng ngày nay là sử dụng các sản phẩm có nguồn gốc tự nhiên, thân thiện môi trường và an toàn cho người sử dụng. Nhóm tác giả đã tiến hành nghiên cứu xác định thành phần hóa học và đánh giá khả năng kháng một số vi khuẩn của tinh dầu sả hương Tây Giang, từ đó đề xuất hướng ứng dụng tinh dầu sả trong các sản phẩm dược phẩm, mỹ phẩm, thực phẩm. Những kết quả thu được sẽ góp phần xây dựng dữ liệu khoa học, định hướng cho việc khai thác và sử dụng có hiệu quả cây sả hương trồng tại huyện Tây Giang, tỉnh Quảng Nam.
Đối tượng và phương pháp nghiên cứu
Đối tượng nghiên cứu
Lá và thân sả hương Tây Giang lấy tại xã Tr’Hy, huyện Tây Giang, tỉnh Quảng Nam. Chọn 03 chủng vi khuẩn thường gặp trong tự nhiên là: B. subtilis, Salmonella và E. coli làm đối tượng nghiên cứu. Chủng gốc được cung cấp từ Trung tâm Ươm tạo Công nghệ và Doanh nghiệp Khoa học Công nghệ – Viện Ứng dụng Công nghệ. Môi trường nuôi cấy LB (Luria Bertani) 1 lít: Agar (20 g), peptone (10 g); cao nấm men (10 g); NaCl (5 g), nước cất vừa đủ.
Phương pháp nghiên cứu
Phương pháp chưng cất: Lá và thân sả hương Tây Giang được chưng cất trên hệ thống thiết bị chưng cất lôi cuốn hơi nước TBCC-50 (hình 1) với các thông số như sau: nhiệt độ 116oC, áp suất 1,2 atm, thời gian 126 phút, tiến hành ngưng tụ ở 40oC và đưa vào thiết bị phân ly tách tinh dầu sả thô. Sau đó, tinh dầu sả thô được tách nước bằng Na2SO4 khan, tiến hành lọc thu được tinh dầu sả hương Tây Giang khan.

Phương pháp xác định hàm lượng và thành phần cấu tử có trong tinh dầu sả hương Tây Giang: Hàm lượng và thành phần cấu tử có trong tinh dầu sả hương Tây Giang được xác định bằng phương pháp sắc ký khí kết hợp khối phổ (GC-MS) [6]. Sử dụng cột mao quản HP5-MS (60 m x 0,25 mm x 0, 25 μm), khí mang: He. Inlet: 250oC, chương trình nhiệt độ (60-240oC, tăng 4oC/phút), năng lượng ion hóa 70 eV, quét mảnh 35-450 m/z. Điều kiện sắc ký khí nối ghép detector ion hóa ngọn lửa (GC-FID): Cột mao quản HP5-MS (60 m x 0,25 mm x 0,25 μm), khí mang: He. Inlet: 250oC, chương trình nhiệt độ (60-240oC, tăng 40/phút), khí mang N2, khí đốt O2 và H2. Ngân hàng phổ HPCH1607, W09N08, NIST chemistry WebBook. Hàm lượng và thành phần cấu tử (%) trong tinh dầu sả là phần trăm diện tích pic của các cấu tử so với tổng diện tích các chất bay hơi của tinh dầu sả.
Phương pháp thử nghiệm hoạt tính kháng khuẩn của tinh dầu sả hương Tây Giang:
Chuẩn bị mẫu: Dầu dừa tinh khiết có khả năng hòa tan hoàn toàn tinh dầu sả hương Tây Giang, là môi trường thuận lợi cho sự phát triển của vi sinh vật, đồng thời không làm ảnh hưởng đến kết quả nghiên cứu. Nhóm nghiên cứu tiến hành sử dụng dầu dừa tinh khiết làm dung môi pha loãng. Tiến hành khảo sát khả năng kháng khuẩn của tinh dầu sả hương Tây Giang ở các thang nồng độ pha loãng lần lượt 5, 10, 20 và 40 lần tương ứng với nồng độ tinh dầu sả hương Tây Giang trong dầu dừa tinh khiết ở nồng độ: 192,6, 96,3, 48,15 và 24,075 mg/ml. Tinh dầu sả hương Tây Giang sử dụng trong thí nghiệm có tỷ trọng 0,963 g/ml.
Thử nghiệm hoạt tính kháng khuẩn: Chủng vi khuẩn được hoạt hóa trước ở 37oC trong 24 giờ ở môi trường LB. Nhỏ 100 μl dịch vi khuẩn đã hoạt hóa lên bề mặt thạch đĩa petri chứa môi trường LB, trải đều. Tiến hành đục lỗ thạch đường kính 6 mm trên đĩa, sau đó cho 50 μl tinh dầu sả hương Tây Giang vào giếng thạch khuếch tán vào môi trường, mang ủ đĩa petri ở 37°C sau 24 giờ, có thể quan sát xuất hiện vòng kháng khuẩn và đọc kết quả. Kích thước vòng kháng khuẩn D chính là khoảng mà vi khuẩn không phát triển được. Kích thước vòng kháng khuẩn càng lớn thì khả năng kháng khuẩn của tinh dầu càng cao và ngược lại. Hoạt tính kháng khuẩn được đánh giá bằng cách đo đường kính (ĐK) vòng ức chế vi sinh vật bằng công thức:
ĐK= D – d (mm)
trong đó: D là đường kính vòng vô khuẩn, d là đường kính lỗ thạch. Thí nghiệm lặp lại 3 lần và lấy giá trị bán kính trung bình.
Phương pháp xử lý số liệu: Kết quả được xử lý bằng phần mềm Excel 2010, các thí nghiệm được lặp lại 3 lần (n=3).
Kết quả và bàn luận
Xác định thành phần hóa học của tinh dầu sả hương Tây Giang
Kết quả xác định thành phần hóa học của tinh dầu sả hương Tây Giang bằng GC-MS, được thể hiện trên bảng 1.

Bảng 1 cho thấy, có 26 thành phần được tìm thấy trong tinh dầu sả hương Tây Giang trong nghiên cứu này. Trong thành phần của tinh dầu sả hương Tây Giang chứa hàm lượng citronellal (48,84%) và geraniol (19,75%) nhiều nhất. Đây là 2 hoạt chất có nhiều dược tính sinh học, thường được sử dụng trong các sản phẩm thương mại như nến, nước hoa, mỹ phẩm, xà phòng và hương liệu. Trong lĩnh vực dược phẩm, citronellal và geraniol đang được quan tâm bởi các hoạt tính sinh học có khả năng ức chế tốt trên các dòng ung thư phổi và ung thư gan. Bên cạnh 2 hoạt chất chính trên, trong tinh dầu sả hương Tây Giang còn một số thành phần khác cũng được tìm thấy: citronellol (9,73%), limonene (3,53%), geranyl acetate (2,24%), citronellyl acetate (1,51%)… Các thành phần chính: citronellal, citronellol và geraniol có sự tương đồng với một số báo cáo trước đây. K.A.F. Rodrigues và cs (2013) đã khảo sát thành phần hóa học của tinh dầu loài Cymbopogon winterianus Jowitt. ở Brazil và phát hiện có 42 cấu tử. Tuy nhiên, cấu tử chính của tinh dầu là: citronellal (26,5%), geraniol (16,2%) và citronellol (7,3%) lại thấp hơn so với tinh dầu sả hương Tây Giang. So sánh 03 cấu tử chính có trong tinh dầu sả hương Tây Giang với TCVN 11426:2016 cho thấy, hàm lượng citronellol cao hơn tiêu chuẩn (8,5%), geraniol gần ngang bằng tiêu chuẩn (20%), hàm lượng citronella cao hơn so với tiêu chuẩn (31%).
Khảo sát hoạt tính kháng khuẩn của tinh dầu sả hương Tây Giang
Kết quả khảo sát hoạt tính kháng khuẩn của tinh dầu sả hương Tây Giang được trình bày trong bảng 2, hình 2-5.

Từ kết quả bảng 2 và các hình 2-5 cho thấy, tinh dầu sả hương Tây Giang có tác dụng kháng khuẩn trên chủng E. coli và B. subtilis ở các nồng độ 192,6, 96,3 và 48,15 mg/ml. Giá trị MIC được xác định là 48,15 mg/ml đối với cả 2 chủng vi khuẩn. Ở nồng độ 24,075 mg/ml, tinh dầu sả hương Tây Giang không có tác dụng kháng khuẩn trên chủng E. coli và B. subtilis. Kết quả bảng 2 cho thấy, tinh dầu sả hương Tây Giang không có tác dụng kháng khuẩn trên chủng Salmonella. Kết quảnghiên cứu phù hợp với kết quả của M.I. Naik và cs (2010) khi nghiên cứu về tinh dầu sả Java ở Ấn Độ cũng có khả năng ức chế 2 chủng vi khuẩn là E. coli và B. subtilis, với giá trịMIC là 60mg/ml. Điều này cho thấy, tinh dầu sả hương Tây Giang có tiềm năng về các chất có hoạt tính kháng khuẩn rất lớn, có thể ứng dụng tốt để điều trị kháng viêm.
Nghiên cứu này đã xác định được các thành phần hóa học và bước đầu xác định hoạt tính kháng một số chủng vi khuẩn của tinh dầu sả hương Tây Giang. Tinh dầu sả hương Tây Giang chứa 26 cấu tử, trong đó có 2 cấu tử chính là citronellal và geraniol có nhiều dược tính sinh học. Tinh dầu sả thể hiện hoạt tính kháng khuẩn trên 2 chủng là B. subtilis và E. coli, với giá trị MIC là 48,15 mg/ml, trong đó hoạt tính kháng khuẩn biểu hiện mạnh hơn trên chủng E. coli và không kháng chủng Salmonella. Kết quả này bước đầu cung cấp thêm thông tin về khả năng kháng khuẩn của tinh dầu sả hương Tây Giang, làm cơ sở cho các nghiên cứu và ứng dụng sau này.
Theo Tạp chí Khoa học và Công nghệ Việt Nam
